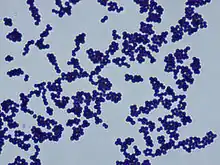
Micrograph showing blue-colored bacteria on a white background

Staphylococcus cohnii
| Staphylococcus cohnii | |
|---|---|
![]() | |
| Staphylococcus cohnii gram stain | |
| Scientific classification | |
| Domain: | Bacteria |
| Phylum: | Bacillota |
| Class: | Bacilli |
| Order: | Caryophanales |
| Family: | Staphylococcaceae |
| Genus: | Staphylococcus |
| Species: | S. cohnii |
| Binomial name | |
| Staphylococcus cohnii Schleifer and Kloos 1975 (Approved Lists 1980) | |
Staphylococcus cohnii is a Gram-positive, coagulase-negative member of the bacterial genus Staphylococcus consisting of clustered cocci. The species commonly lives on human skin; clinical isolates have shown high levels of antibiotic resistance.[1] A strain of S. cohnii was found to contain a mobile genetic element very similar to the staphylococcal cassette chromosome encoding methicillin resistance element seen in Staphylococcus aureus.[2]
References
- ↑ Garza-Gonz Lez, E; Morfin-Otero, R; Mart Nez-V; Zquez, MA; Gonzalez-Diaz, E; Gonz Lez-Santiago, O; Rodr Guez-Noriega, E (December 2011). "Microbiological and molecular characterization of human clinical isolates of Staphylococcus cohnii, Staphylococcus hominis, and Staphylococcus sciuri". Scandinavian Journal of Infectious Diseases. 43 (11–12): 930–6. doi:10.3109/00365548.2011.598873. PMID 21851333. S2CID 26219248.
- ↑ Zong, Zhiyong; Lü, Xiaoju; DeLeo, Frank R. (17 November 2010). "Characterization of a New SCCmec Element in Staphylococcus cohnii". PLOS ONE. 5 (11): e14016. Bibcode:2010PLoSO...514016Z. doi:10.1371/journal.pone.0014016. PMC 2984492. PMID 21103346.
Further reading
Hu, XinJun; Li, Ang; Lv, LongXian; Yuan, Chunhui; Guo, Lihua; Jiang, Xiawei; Jiang, Haiyin; Qian, GuiRong; Zheng, Beiwen; Guo, Jing; Li, LanJuan (2014). "High quality draft genome sequence of Staphylococcus cohnii subsp cohnii strain hu-01". Standards in Genomic Sciences. 9 (3): 755–762. doi:10.4056/sigs.5429581. PMC 4149010. PMID 25197460.
External links